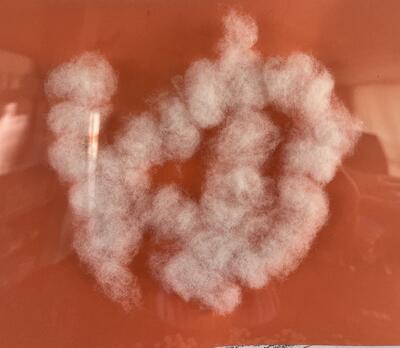

2024年6月の記事一覧
グローバル人材の育成~ふるさと教育の充実をとおして~
6月18、19日の2日間、文化庁芸術鑑賞事業により能楽のワークショップを開催しました。能楽(能や狂言)は、室町時代より600年以上受け継がれてきている日本の伝統芸能です。講師の先生は、鼻ぐり井手を題材にした狂言を創作された劇作家の山川さんをはじめ、日本全国から集まられた能楽師の方々です。講話からは、長い年月の中、その文化が人から人へと伝承されてきたこと、笑いの文化を大事にしながら、たくましく生き抜いてきた日本人のたくましさなどを感じることができました。また、笛や鼓(つづみ)の演奏体験や発声・演技の体験を通して、その難しさ・奥深さを感じ取っていた子どもたちでした。
今、ウクライナをはじめ、世界のいたるところで紛争等が起き、尊い命が奪われている現実があります。これからの世界を築いていくのは、目の前の子どもたちです。グローバル人材とは、いろいろな人々と協働して、困難な課題を解決していく人材です。違いを認め合って、互いの文化等を尊重し合って、手を取り合う力が必要です。その力は、まず自分たちが生まれたふるさと、そして日本のすばらしさを知ることが重要です。
日本の文化や、そこに脈々と流れ続けた日本人の魂のすばらしさを理解した子どもたちが、将来、世界中の人々とつながって活躍し、すてきな未来を築いてくれることと信じています。
子どもたちの「瞳が輝く」授業づくりを!~工夫した学習活動で授業が変わる~
私が小学生の頃の通知表には、必ず「落ち着きがない」と書かれています。その落ち着きのない少年森田は、漢字も苦手でした。1・2年の担任の先生は、よく私を放課後に残して、徹底的に漢字の書き取り練習をさせてくださいました。3・4年の担任の先生は、私が文字に興味を持てるように、土曜日の昼から習字を無償で教えてくださいました。そうした恩師の深い愛情に育てられ、ついに6年生の漢字小テスト(10問)で、初めて100点を取ったことを今でも覚えています。
本町の二殿教育長がよくおっしゃられることは、「目の前の子どもたちに、これでもかの愛情を!」ということです。「教育は人なり」と言われますが、やはり、子どもたちの人生にとって、教職員の深い愛情は、欠かすことのできない重要な教育環境なのです。
本校の1年生教室には、その「これでもかの愛情」がたくさん詰まっています。1年生の最重要学習内容は「文字の学習」です。
これから何十年と続く子どもたちの人生を豊かにしていくのが「文字の獲得」です。だからこそ、稲葉教諭は、様々な工夫した学習活動により、楽しみながら、体感しながら、子どもたちが文字を獲得していけるようにしています。
クラス全員の手形を集めて作った「て」の字。針金と綿で作った「ゆ」の字。アルミホイールをねじってかたどった「ね」の字、
井野教諭が『子どもたちが楽しみながら覚えられるように』との思いで作った「アンパンマン指人形ひらがな表」など、「これでもかの愛情」に包まれています。本校の教室では、子どもたちの「瞳が輝く」授業づくりが日々展開されています。
子どもと本の世界をつなぐ~読み聞かせボランティアさんの思いから~
今年も、読み聞かせボランティアの方々による「本の読み聞かせ」が始まりました。皆さんは、事前に2冊3冊と、読み聞かせの練習をして来られていました。そこには、「ひとりでも多くの子どもたちに、絵本や物語の面白さを伝えたい。本を読むことで、わくわくする感動を覚えてほしい。知恵と勇気、そして、生きることの大切さを知ってほしい。」という願いがあられるのではと拝察しております。
一冊の本との出会いから様々なことを学び、心も成長してくれることでしょう。
すてきな思いに触れて
今朝(6月17日)も、二ノ文様から、きれいなお花をいただきました。
朝、交通安全指導をしていると、きれいなお花を持って歩いて学校に届けてくださるお姿をお見かけしました。すぐに歩み寄って、「いつもありがとうございます。」とお礼を申し上げると、このようにおっしゃいました。
「子どもたちが喜んでくれることが、母や私の幸せです。」(二ノ文様は、母娘で届けてくださっています。)
誰かの笑顔のために・・・。人の喜びが自分の幸せ・・・。なんて、すてきなことでしょう。
自分も、『こんなすてきな人になりたいなぁ』と強く思ったところでした。
早速、朝の会議で、この二ノ文様の思いを子どもたちに伝え、その価値について各学級で触れるように、職員に話をしました。
本校を愛してくださる皆様のお気持ち等について、一つ一つ立ち止まって触れることで、子どもたちの感性を育てていきます。
粘り強く、たくましい子に
暑い季節を迎え、今年もプール開きを行いました。速く、長く泳げるようになることも大事ですが、自分の命を守る力をつけることが重要です。さらに、苦手なことや苦しいことでも、目標を持って粘り強く取り組み、さらなる自身の成長へとつないでいくたくましさを身につけてほしいと願っています。
ふるさとに誇りを持つ子どもに
毎年恒例の「子どもガイド養成講座」の開講式を実施しました。今年も、「菊陽町文化財ボランティアガイドの会」の松永様、矢野様、上村様、有働様に講師としておいでいただきます。また、開講式には岡本生涯学習課長もおみえになり、3・4年の子どもたちへ、ガイドの証である帽子を贈呈してくださいました。開講式のあと、基礎講座①「加藤清正公の水物語」を学習しました。3年生にとっては初めての本講座。秋には、ガイド活動や本講座をベースにした音楽劇を披露することになります。このような形でふるさとについて学習できることは、本当に幸運なことです。これからの子どもたちの学習の様子がとても楽しみです。
小規模校の強みを生かす!~縦割りのつながりをとおして、感性を育てる~
私は、校長室の窓から見える光景が大好きです。運動場で、子どもたちがブランコに乗ったり、鬼ごっこをしたり、サッカーをしたり、虫取りをしたりと、その遊びは様々です。よく見ると、単学年ではなく、様々な学年の子が共に遊んでいることに気付きます。高学年が低学年をおんぶしたり、抱っこしたり。サッカーでも、上の学年の子が下の学年の子にやさしくパスを回してシュートをさせたりしています。そこには、「見守る」という意識が確かに存在します。決して「してやってる」という上から目線ではなく、その場その時間を一緒に過ごすことに「楽しみ」を覚えているのです。
これは、本校独自の「サウスくんデイ」の効果でもあります。「サウスくんデイ」とは、全校児童が縦割り班(どの班も全ての学年児童で構成されている班)に分かれて、自分たちで遊びや掃除等について考え、一緒に活動する日です。1年生から6年生までが、一緒に話し合い、遊び、給食を食べ、掃除をするためには、お互いのことを考えたり、折り合いをつけたり、より協力する意識を持たなければなりません。そうした縦割りのつながりの中で、自分の思いを相手に伝えたり、相手の気持ちを考え行動したりできる感性が育っています。だからこそ、毎日の学校生活の中でもつながり、共に過ごす楽しさを感じ、笑顔が溢れているのです。
6年生のリーダーシップの下、主体的活動が進められています!
守られ、愛されていることの幸せ
本校の玄関には、いつもきれいな花が絶えることがありません。これは、近くにお住まいの二ノ文様が、いつも学校に届けてくださるお花です。毎日、毎日、この美しい花が、子どもたちや来客の方々、そして職員を迎えてくれます。このような潤いある環境を提供していただいている二ノ文様に深く感謝申し上げます。
キリスト教の行事のひとつである花の日は、「6月の第2日曜日」です。花の日とは、花も人も神様から与えられ、守られ、愛されていることを感謝する日だそうです。
宗教に関係なく、この学校が、地域の方々から守られ、愛されていることをつくづく感じる毎日であり、その中で暮らし、教育に取り組むことができる幸せに、感謝の思いでいっぱいです。
芋の苗植え~学年の枠を越えて~
グリーンパークで芋の苗植えを行いました。苗植えが実現できるまでずっと、保護者である東様が畝づくり、肥料まき、マルチ張り、植え方の指導等のお世話をしてくださいました。
苗植えは、2年生と5年生、1年生と6年生と、学年の枠を越えて一緒に植えていきました。小規模校ならではの取組です。下学年の様子を見守る高学年のあたたかい眼差し、表情。全くの抵抗感や緊張感なく、屈託のない笑顔をお兄さん・お姉さんに見せる1・2年生の姿。こうした子どもたちの姿そして体験の場を支えていただいていることに、感謝の念しかございません。
天まで届け!ゴーヤカーテン ~ 4年生の苗植え~
4年生が、毎年恒例のゴーヤの苗を植えました。ゴーヤカーテンを作るという、自分たちにできる環境を守る具体的な取組です。こうした体験による学びは地域学校協働活動によるものです。この活動も多くの方々に支えていただいています。苗を提供していただいている紫藤様、植え方の指導をしてくださる南部町民センターの冨永センター長、地域と学校を結ぶ地域学校協働活動推進員の内田様。たくさんの方々に見守られて、4年生は苗を大切そうに両手で持って、丁寧に植えていました。
4年生は毎日ゴーヤの成長を観察し、水をやり、嬉しそうに育てています。4年生、そして、活動を支えてくださって
いる方々の思いを受けて、天まで届くようにすくすくと育ってほしいものです。